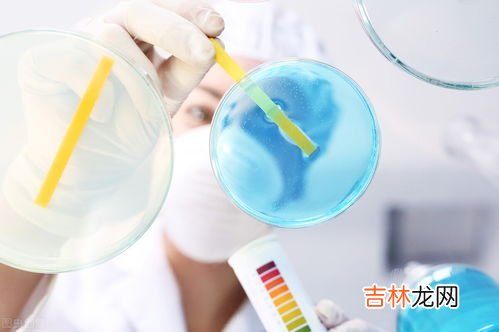

1、湿厕巾是擦什么的?湿厕巾是擦大便或者是小便上的 。湿厕纸相对于普通干纸巾,具有洁净功能和舒适特性,因此逐渐成为厕纸界的新产品 。事实上,湿厕纸并非是中国首创 。在欧美发达国家,湿厕纸早已是普遍使用的家居必备品 。湿厕纸除了能擦掉干纸擦不掉的污垢之外,还可以有效擦除99.9%的细菌 。同时湿厕纸主要由原生木浆构成,配合适中水分,触感柔软舒适 。
湿厕巾正确使用方法
由于湿厕巾湿含有水分的,所以要避免将湿厕巾放置在阳光直射或者靠近热源、火源的地方,要将其放到阴凉通风处 。在使用湿厕巾的时候,尽量不要过于用力,不然也会使得湿厕巾发生变形和破裂,从而破坏湿厕巾的使用质感 。将湿厕巾拿出来后,需要立即使用,才能起到清洁杀菌的效果 , 否则会导致湿厕巾的水分流失,降低使用效果 。
文章插图
文章插图
2、湿厕纸怎么用【湿厕纸是干什么用的,湿厕巾是擦什么的?】在上完厕所之后 , 按照使用普通厕纸的方法来用它擦屁股即可 。湿厕纸是一种湿润、柔软而且更具清洁力的物品,而且它在使用之后可以直接丢入厕所中,因为它可以被冲散、分解 , 不用担心它会堵住厕所 。
1、湿厕纸顾名思义就是湿润的厕纸,这种纸看起来和湿纸巾非常的相似,我们平时如果要使用湿厕纸的话可以只需要在上完厕所之后 , 按照用使用普通厕纸的方法来用它擦屁股即可 。
2、我们平时在上完厕所之后使用湿厕纸来擦拭屁股会有更好的清洁效果,而且它相对于一些干的纸而言也更加的柔软、亲和,不会让我们的皮肤受到损伤 , 所以现在很多人都开始使用湿厕纸 。
3、除此之外,湿厕纸在使用完之后还可以直接丢入厕所中,因为湿厕纸是可以被冲散、分解的,所以我们在使用湿厕纸的时候是不用像使用湿巾纸时那样担心它会堵住厕所的 。

文章插图
文章插图
3、洁厕纸是干什么用的 洁厕纸是什么现在很多人家里都会买洁厕纸来用的,这个洁厕纸感觉和湿巾是差不多的,那么它的作用究竟是什么?洁厕纸是什么制作而成的呢?
洁厕纸是干什么用的
湿厕纸,顾名思义是湿的厕纸 , 湿厕纸相对干纸巾更具有功能性和舒适体验性 。主要体现在:湿厕纸清洁更彻底,湿厕纸擦拭更舒爽,湿厕纸中含有的中药、植物精华 , 更具有一定的消毒、杀菌、去异味,保健功能 。湿厕纸是干厕纸的又一创造性的升级品 。
洁厕纸是什么
每当痔疮犯的时候,用湿湿的纸巾不会让屁屁很痛 。特别是产后特别容易便秘 , 这时候用湿纸巾也会起到镇痛的作用,因为它湿湿的,凉凉的 。还有一个特别的情况 , 就是在吃火辣的火锅之后,用湿湿的纸巾就不会那么辣那么痛 。
洁厕纸和湿巾的区别
1.材质不同:优质的湿厕纸主要由原生木浆构成,可以在马桶和下水道中分解,而湿巾是采用无纺布制作的,无法在马桶中分解 。
2.作用不同:优质的湿厕纸通过了阴道粘膜测试,PH呈弱酸性,适合私处和各类敏感人士适用,而湿巾并不是为私处特别制作 。
洁厕纸什么牌子好
2022年厕所卫生纸十大品牌排行榜,前十名分别是维达/Vinda、洁柔、清风、植护、泉林本色、一晨、心相印、斑布/BABO、顺清柔、惠寻。

文章插图
文章插图
4、请问湿厕纸是干什么用的,很好的个人卫生必备用品吗?湿厕纸显然是擦PP用的,它可以有效擦除卷纸的残留污垢,一般还不含杀菌剂,荧光剂 , 非常柔软,我用的舒洁的,维达也用过,感觉舒洁的纸质好点,如果有痔疮感觉用湿厕纸很好的 。日常出去玩带一包这个感觉很方便的 , 擦手也可以 , 我不太喜欢湿巾,有的湿巾的无纺布是会掉线的 。
湿厕纸是用来擦PP的,痔疮患者的福音,超级好用,个人建议干湿结合 , 先用普通厕纸擦一下,然后用湿厕纸 , 很干净贼舒服,我推荐舒洁的,他们家还有经期专门用的 , 爱爱的时候也可以用,超级方便
湿厕纸顾名思义就是擦屁股用的,上面有个厕字怎么可能是擦桌子用的 , 上面回答的那位朋友是不是自己也弄错了!买这个上面都有用途的 。湿纸巾跟湿厕纸不是一回事,不要误导别人呀!
这应该是擦拭桌子或者家居用品用的一次性的清洁纸 。这应该和平时生活用的卫生纸还是有区别的,并不是作为如厕用的卫生纸 , 可能你的理解有误区 。

文章插图
文章插图
5、湿厕纸是干嘛的好二三四湿厕纸,它是用来上厕所的,它属于厕纸的一种,准确的说,它是一种可冲散的湿式卫生纸 。顾名思义它是湿的厕纸,相对平常的干纸巾来说,功能性更多以及使用时更舒适 。
它主要体现在,湿厕纸清洁比普通厕纸更加彻底,湿厕纸中含有的中药、植物精华等有保健的功能 , 并且使用湿厕纸擦拭更舒爽,此外它还具有一定的消毒去异味功能 。它是在干厕纸的基础上,一种创造性的升级品 。
湿厕纸有以下的优点 。它有保健功能 , 它能够有效的避免细菌滋生引起的痔疮疾?。?妇科疾病等各种肛门卫生问题,进而达到杀菌和除菌以及消除异味的作用 。同时 , 湿厕纸用起来更加舒适,便后清洁,一擦如洗 。
在超市选购湿厕纸的时候 , 需要注意以下细节 。第一个细节,学会看基布,现在市面上的湿厕纸主要分为无尘纸和原生木浆构成的专业湿厕纸基布两种类型 。优质的湿厕纸大多主要用天然亲肤的原生木浆做的 , 它配合高质量的PP纤维使用,特别的柔软亲肤 。第二个,看除菌能力 。好的的湿厕纸理论上能够有效擦除99.9%的细菌 , 同时采用的除菌机理是物理除菌,也就是说细菌是在擦拭完之后是被带走在纸上 。
基于湿厕纸的这些优点,湿厕纸经常被用来取代生活中常用的那些厕纸 。因湿厕纸的保健和除菌杀菌等功效,以及质地柔软等优点,极大的满足了人们的生活需求和舒适的体验 。
经验总结扩展阅读
- 仿制手表都是哪里出的,深圳买高仿手表的地方在哪
- 丝绸之路在什么时期繁荣,古代海上丝绸之路进入鼎盛时期是在
- 几万米以上算太空,10万米高空是太空吗 10万米高空到太空了吗?
- 小数的意义是什么,小数的意义是什么
- 供果火龙果应该供几个,佛教里桌上供的水果应该是摆放几个?
- 10块钱图片背面是哪里,10元背面的图案是什么地方?
- 烘焙定妆是什么意思,烘焙定妆法能定妆多久
- 下水道下水慢怎么办,马桶堵了但是还能下水,水很慢怎么解决?
- 沪瑞线是国道还是高速,沪昆高速起点和终点在哪里?
- 从化是哪个省的城市,从化属于广州市吗?
